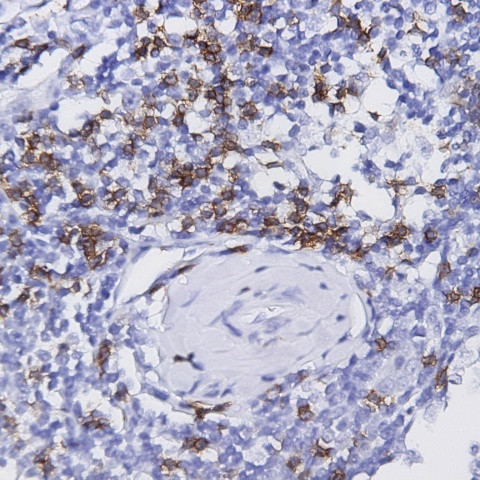
Perforin Antibody in Immunohistochemistry (Paraffin) (IHC (P))

Search
AbboMax
Perforin Monoclonal Antibody (dG9)
{{$productOrderCtrl.translations['antibody.pdp.commerceCard.promotion.promotions']}}
{{$productOrderCtrl.translations['antibody.pdp.commerceCard.promotion.viewpromo']}}
{{$productOrderCtrl.translations['antibody.pdp.commerceCard.promotion.promocode']}}: {{promo.promoCode}} {{promo.promoTitle}} {{promo.promoDescription}}. {{$productOrderCtrl.translations['antibody.pdp.commerceCard.promotion.learnmore']}}
图: 1 / 1
Perforin Antibody (604-820) in IHC (P)

产品信息
604-820
种属反应
宿主/亚型
分类
类型
克隆号
抗原
偶联物
形式
浓度
纯化类型
保存液
内含物
保存条件
运输条件
产品详细信息
Positive control: Spleen
Cellular location: Secreted, Cell membrane.
靶标信息
Perforin is one of the major cytolytic proteins of cytolytic granules. Perforin is a cytolytic mediator and is stored in and released by cytoplasmic granules. Moreover, perforin is involved in immune defense against tumors and virus infections as mediated by cytotoxic lymphocytes. Perforin is a 555 amino acid protein with a 21 amino acid signal peptide, and has a molecular weight of 70 to 75 kD. Perforin is a pore forming protein with a mechanism of transmembrane channel formation similar to C9, and homology between perforin and C9 have been demonstrated. Studies show that perforin is expressed only in killer cell lines and not in helper T lymphocytes or other tumor cells tested. Perforin is known to be a key effector molecule for T-cell- and natural killer-cell-mediated cytolysis. Defects in the perforin gene cause familial hemophagocytic lymphohistiocytosis type 2 (HPLH2), a rare and lethal autosomal recessive disorder of early childhood. Alternative splicing results in multiple transcript variants of perforin.
仅用于科研。不用于诊断过程。未经明确授权不得转售。
篇参考文献 (0)
生物信息学
蛋白别名: Cytolysin; lymphocyte pore forming protein; Lymphocyte pore-forming protein; OMAK; OTTHUMP00000019759; P1; perforin 1 (pore forming protein); Perforin-1; Perforin1; PFP; PGFL; PIGF; PIGF-2; PLGF; PRF1 (pore forming protein 1); RP11-710A11.3
基因别名: FLH2; HPLH2; P1; PFN1; PFP; PRF1
UniProt ID: (Human) P14222
Entrez Gene ID: (Human) 5551